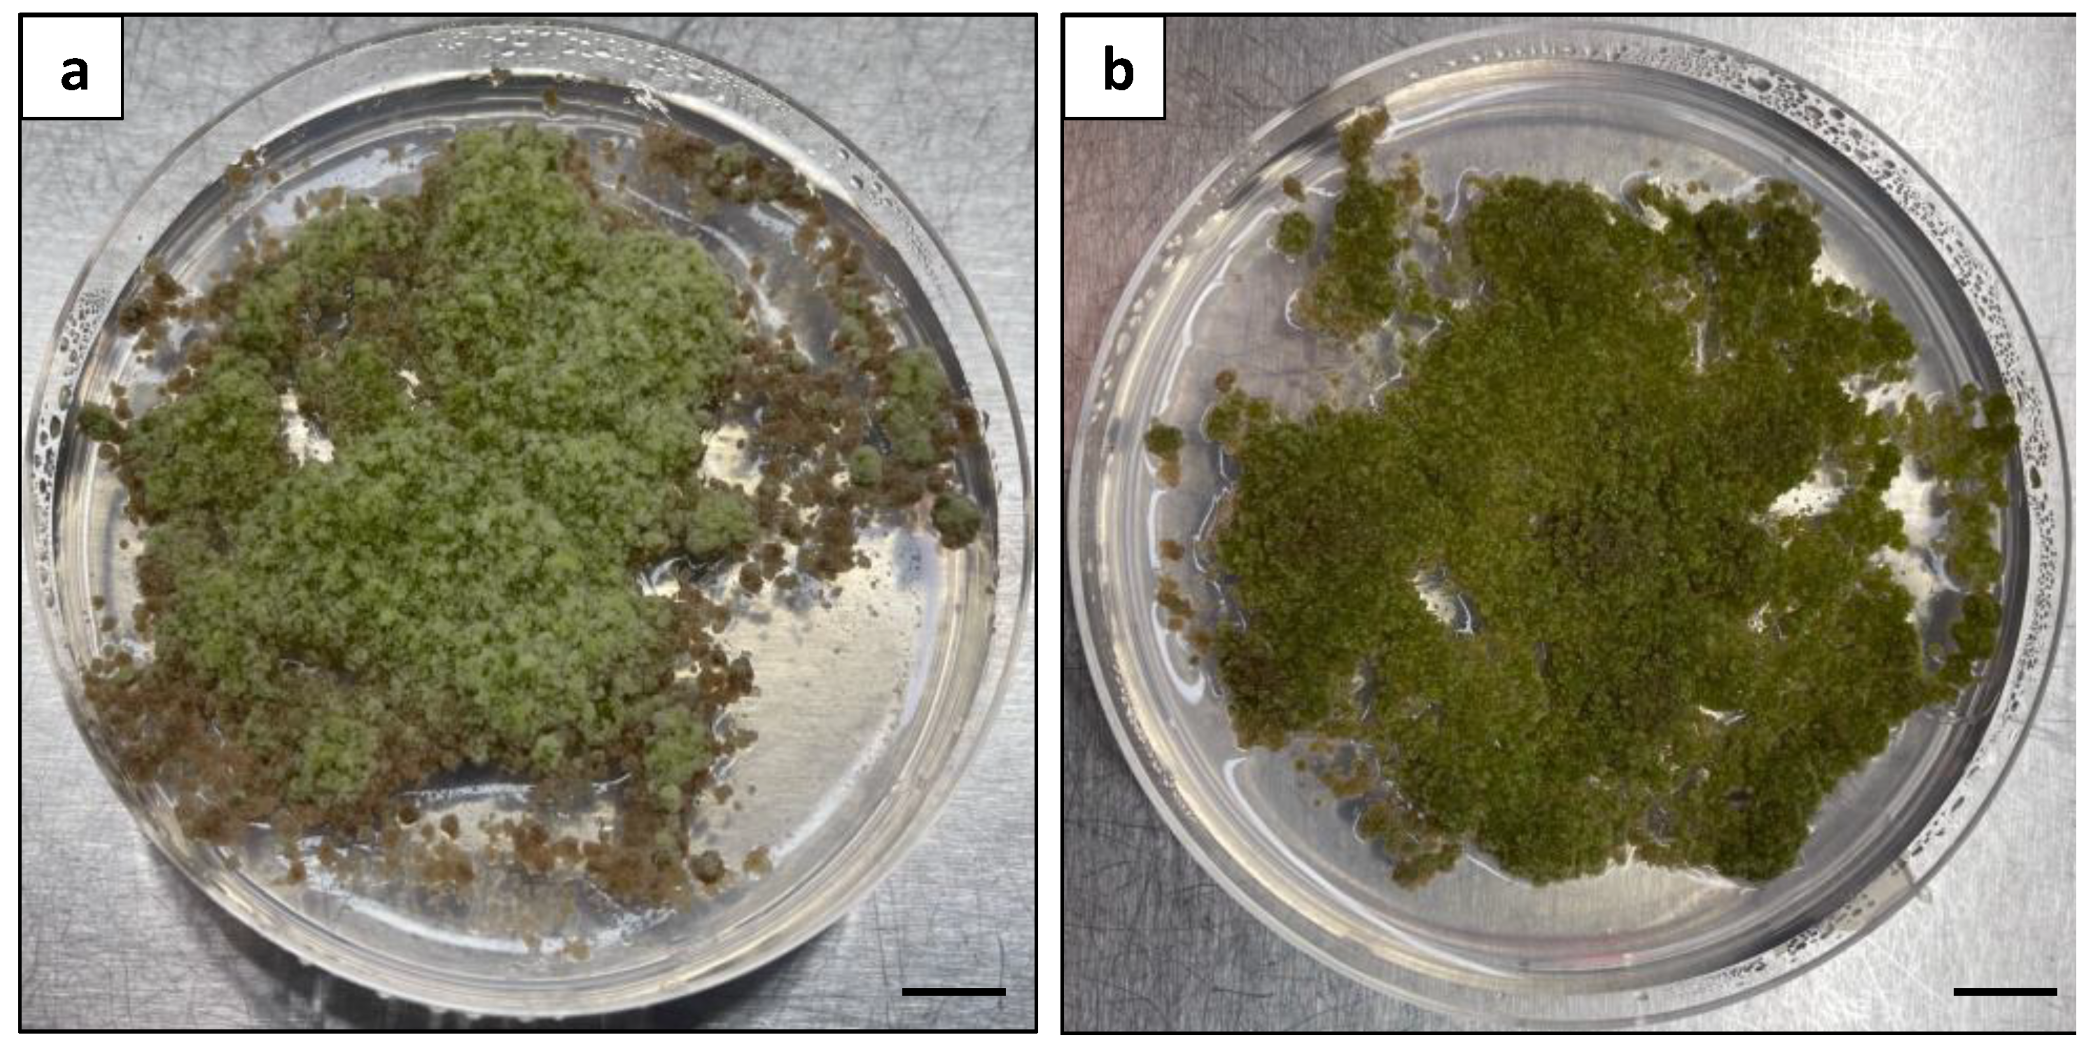
Plants 13 00040 g011

First Report on Mesophyll Protoplast Isolation and Regeneration System for the Duboisia Species
Abstract
1. Introduction
2. Results
2.1. Protoplast Isolation
2.1.1. Optimisation of Protoplast Digestion
Factor 1–Leaf Strip Size
Factor 2–Physical Treatment
Factor 3–Incubation Conditions
Factor 4–Digestion Duration
Factor 5–Enzyme Concentration
2.2. Plant Regeneration from Protoplasts
2.2.1. Selection of Culture System and Basal Medium
2.2.2. Microcalli Induction and Proliferation
2.2.3. Plant Regeneration from Callus
2.3. Growth Evaluation of Protoplast-Derived Plants
2.3.1. Plant Height
2.3.2. Stem Girth
2.3.3. Number of Leaves and Canopy
2.3.4. Number of Branches
3. Discussion
4. Materials and Methods
4.1. Protoplast Isolation
4.1.1. Plant Materials and General Methods
4.1.2. Optimisation of Protoplast Digestion
Factor 1–Leaf Strip Size
Factor 2–Physical Treatment
Factor 3–Incubation Conditions
Factor 4–Digestion Duration
Factor 5–Enzyme Concentration
4.1.3. Protoplast Collection and Purification
4.1.4. Protoplast Yield and Viability Test
4.2. Plant Regeneration from Protoplasts
4.2.1. Selection of Culture System and Basal Medium
4.2.2. Microcalli Induction and Proliferation
4.2.3. Plant Regeneration from Calli
4.3. Growth Evaluation of Protoplast-Derived Plants
4.4. Data Analysis
5. Conclusions
Author Contributions
Funding
Data Availability Statement
Conflicts of Interest
References
- Davey, M.R.; Anthony, P.; Power, J.B.; Lowe, K.C. Plant Protoplast Technology: Current Status. Acta Physiol. Plant. 2005, 27, 117–130. [Google Scholar] [CrossRef]
- Murch, S.J.; Saxena, P.K. Somatic Cell Fusion: Relevance to Medicinal Plants. In Development of Plant-Based Medicines: Conservation, Efficacy and Safety; Saxena, P.K., Ed.; Springer: Dordrecht, The Netherlands, 2001; pp. 167–181. ISBN 978-94-015-9779-1. [Google Scholar]
- Saul, M.W.; Potrykus, I. Direct Gene Transfer to Protoplasts: Fate of the Transferred Genes. Dev. Genet. 1990, 11, 176–181. [Google Scholar] [CrossRef]
- Metje-Sprink, J.; Menz, J.; Modrzejewski, D.; Sprink, T. DNA-Free Genome Editing: Past, Present and Future. Front. Plant Sci. 2019, 9, 1957. [Google Scholar] [CrossRef] [PubMed]
- Wolter, F.; Puchta, H. Knocking out Consumer Concerns and Regulator’s Rules: Efficient Use of CRISPR/Cas Ribonucleoprotein Complexes for Genome Editing in Cereals. Genome Biol. 2017, 18, 43. [Google Scholar] [CrossRef] [PubMed]
- Reed, K.M.; Bargmann, B.O.R. Protoplast Regeneration and Its Use in New Plant Breeding Technologies. Front. Genome Ed. 2021, 3, 734951. [Google Scholar] [CrossRef] [PubMed]
- Rezazadeh, R.; Harrison, D.K.; Williams, R.R. Intraspecific Somatic Hybridization of Mango (Mangifera indica L.) through Protoplast Fusion. JAH 2011, 13, 101–107. [Google Scholar] [CrossRef]
- Lynch, P.T.; Benson, E.E. Cryopreservation: A Method for Maintaining Plant Regeneration Capability of Rice Cell Suspension Cultures. In Rice Genetics II; Rice Genetics Collection; World Scientific Publishing Company: Singapore, 2008; Volume 2, pp. 321–332. ISBN 978-981-281-866-9. [Google Scholar] [CrossRef]
- Kim, J.B.; Bergervoet, J.E.M.; Raemakers, C.J.J.M.; Jacobsen, E.; Visser, R.G.F. Isolation of Protoplasts, and Culture and Regeneration into Plants in Alstroemeria. Vitr. Cell. Dev. Biol. Plant 2005, 41, 505–510. [Google Scholar] [CrossRef]
- Sheen, J. Signal Transduction in Maize and Arabidopsis Mesophyll Protoplasts. Plant Physiol. 2001, 127, 1466–1475. [Google Scholar] [CrossRef]
- Gupta, H.S.; Pattanayak, A. Plant Regeneration from Mesophyll Protoplasts of Rice (Oryza sativa L.). Nat. Biotechnol. 1993, 11, 90–94. [Google Scholar] [CrossRef]
- Partovi, R.; Farahani, F.; Sheidai, M.; Satari, T.N. Isolation of Protoplasts Banana (Musa Acuminate Colla) Cvs. Dwarf Cavendish and Valery and Research Morphological and Cytogenetic Their Plantlets Regenerated. Cytologia 2017, 82, 395–401. [Google Scholar] [CrossRef]
- Fu, Y.; Jia, S.; Lin, Y. Plant Regeneration from Mesophyll Protoplast Culture of Cabbage (Brassica oleracea Var ‘Capitata’). Theoret. Appl. Genet. 1985, 71, 495–499. [Google Scholar] [CrossRef] [PubMed]
- Russell, J.A. Advances in the Protoplast Culture of Woody Plants. In Micropropagation of Woody Plants; Ahuja, M.R., Ed.; Forestry Sciences; Springer: Dordrecht, The Netherlands, 1993; pp. 67–91. ISBN 978-94-015-8116-5. [Google Scholar] [CrossRef]
- d’Utra Vaz, F.B.; dos Santos, A.V.P.; Manders, G.; Cocking, E.C.; Davey, M.R.; Power, J.B. Plant Regeneration from Leaf Mesophyll Protoplasts of the Tropical Woody Plant, Passionfruit (Passiflora edulis Fv Flavicarpa Degener.): The Importance of the Antibiotic Cefotaxime in the Culture Medium. Plant Cell Rep. 1993, 12, 220–225. [Google Scholar] [CrossRef] [PubMed]
- Wallin, A.; Johansson, L. Plant Regeneration from Leaf Mesophyll Protoplasts of in vitro Cultured Shoots of a Columnar Apple. J. Plant Physiol. 1990, 135, 565–570. [Google Scholar] [CrossRef]
- Umate, P.; Rao, K.V.; Kiranmayee, K.; Sree, T.J.; Sadanandam, A. Plant Regeneration of Mulberry (Morus indica) from Mesophyll-Derived Protoplasts. Plant Cell Tiss Organ Cult. 2005, 82, 289–293. [Google Scholar] [CrossRef]
- Azad, M.A.K.; Yokota, S.; Ishiguri, F.; Yoshizawa, N. Plant Regeneration from Mesophyll Protoplasts of a Medicinal Plant, Phellodendron amurense Rupr. Vitr. Cell. Dev. Biol. Plant 2006, 42, 502–507. [Google Scholar] [CrossRef]
- Barnard, C. The Duboisias of Australia. Econ. Bot. 1952, 6, 3–17. [Google Scholar] [CrossRef]
- Besher, S.; Al-Ammouri, Y.; Murshed, R. Production of Tropan Alkaloids in the in vitro and Callus Cultures of Hyoscyamus aureus and Their Genetic Stability Assessment Using ISSR Markers. Physiol. Mol. Biol. Plants 2014, 20, 343–349. [Google Scholar] [CrossRef][Green Version]
- Zhang, L.; Ding, R.; Chai, Y.; Bonfill, M.; Moyano, E.; Oksman-Caldentey, K.-M.; Xu, T.; Pi, Y.; Wang, Z.; Zhang, H. Engineering Tropane Biosynthetic Pathway in Hyoscyamus niger Hairy Root Cultures. Proc. Natl. Acad. Sci. USA 2004, 101, 6786–6791. [Google Scholar] [CrossRef]
- Foley, P. Duboisia Myoporoides: The Medical Career of a Native Australian Plant. Hist. Rec. Aust. Sci. 2006, 17, 31–69. [Google Scholar] [CrossRef]
- Kitamura, Y. Regeneration of Plants from Protoplasts of Duboisia. In Plant Protoplasts and Genetic Engineering IV; Bajaj, Y.P.S., Ed.; Biotechnology in Agriculture and Forestry; Springer: Berlin/Heidelberg, Germany, 1993; pp. 18–31. ISBN 978-3-642-78037-0. [Google Scholar] [CrossRef]
- Kitamura, Y.; Morikawa, T.; Miura, H. Isolation and Culture of Protoplasts from Cell Suspension Cultures of Duboisia myoporoides with Subsequent Plant Regeneration. Plant Sci. 1989, 60, 245–250. [Google Scholar] [CrossRef]
- Liang, Z.; Chen, K.; Li, T.; Zhang, Y.; Wang, Y.; Zhao, Q.; Liu, J.; Zhang, H.; Liu, C.; Ran, Y.; et al. Efficient DNA-Free Genome Editing of Bread Wheat Using CRISPR/Cas9 Ribonucleoprotein Complexes. Nat. Commun. 2017, 8, 14261. [Google Scholar] [CrossRef]
- Park, J.; Choi, S.; Park, S.; Yoon, J.; Park, A.Y.; Choe, S. DNA-Free Genome Editing via Ribonucleoprotein (RNP) Delivery of CRISPR/Cas in Lettuce. In Plant Genome Editing with CRISPR Systems: Methods and Protocols; Qi, Y., Ed.; Methods in Molecular Biology; Springer: New York, NY, USA, 2019; pp. 337–354. ISBN 978-1-4939-8991-1. [Google Scholar]
- Oksman-Caldentey, K.-M.; Strauss, A. Somaclonal Variation of Scopolamine Content in Protoplast-Derived Cell Culture Clones of Hyoscyamus muticus. Planta Methods 1986, 52, 6–12. [Google Scholar] [CrossRef]
- Etienne, H.; Bertrand, B. Somaclonal Variation in Coffea Arabica: Effects of Genotype and Embryogenic Cell Suspension Age on Frequency and Phenotype of Variants. Tree Physiol. 2003, 23, 419–426. [Google Scholar] [CrossRef]
- Wu, F.-H.; Shen, S.-C.; Lee, L.-Y.; Lee, S.-H.; Chan, M.-T.; Lin, C.-S. Tape-Arabidopsis Sandwich—A Simpler Arabidopsis Protoplast Isolation Method. Plant Methods 2009, 5, 16. [Google Scholar] [CrossRef] [PubMed]
- Liu, Y.; Xue, Y.; Tang, J.; Chen, J.; Chen, M. Efficient Mesophyll Protoplast Isolation and Development of a Transient Expression System for Castor-Oil Plant (Ricinus communis L.). Biol. Futur. 2019, 70, 8–15. [Google Scholar] [CrossRef] [PubMed]
- Kanai, R.; Edwards, G.E. Separation of Mesophyll Protoplasts and Bundle Sheath Cells from Maize Leaves for Photosynthetic Studies. Plant Physiol. 1973, 51, 1133–1137. [Google Scholar] [CrossRef] [PubMed]
- Shan, Q.; Wang, Y.; Li, J.; Gao, C. Genome Editing in Rice and Wheat Using the CRISPR/Cas System. Nat. Protoc. 2014, 9, 2395–2410. [Google Scholar] [CrossRef]
- Cheng, N.; Nakata, P.A. Development of a Rapid and Efficient Protoplast Isolation and Transfection Method for Chickpea (Cicer arietinum). MethodsX 2020, 7, 101025. [Google Scholar] [CrossRef]
- Nanjareddy, K.; Arthikala, M.-K.; Blanco, L.; Arellano, E.S.; Lara, M. Protoplast Isolation, Transient Transformation of Leaf Mesophyll Protoplasts and Improved Agrobacterium-Mediated Leaf Disc Infiltration of Phaseolus vulgaris: Tools for Rapid Gene Expression Analysis. BMC Biotechnol. 2016, 16, 53. [Google Scholar] [CrossRef]
- Jeong, Y.Y.; Lee, H.-Y.; Kim, S.W.; Noh, Y.-S.; Seo, P.J. Optimization of Protoplast Regeneration in the Model Plant Arabidopsis thaliana. Plant Methods 2021, 17, 21. [Google Scholar] [CrossRef]
- Sangra, A.; Shahin, L.; Dhir, S.K. Optimization of Isolation and Culture of Protoplasts in Alfalfa (Medicago sativa) Cultivar Regen-SY. Am. J. Plant Sci. 2019, 10, 1206. [Google Scholar] [CrossRef]
- Ren, R.; Gao, J.; Lu, C.; Wei, Y.; Jin, J.; Wong, S.-M.; Zhu, G.; Yang, F. Highly Efficient Protoplast Isolation and Transient Expression System for Functional Characterization of Flowering Related Genes in Cymbidium Orchids. Int. J. Mol. Sci. 2020, 21, 2264. [Google Scholar] [CrossRef] [PubMed]
- Moon, K.-B.; Park, J.-S.; Park, S.-J.; Lee, H.-J.; Cho, H.-S.; Min, S.-R.; Park, Y.-I.; Jeon, J.-H.; Kim, H.-S. A More Accessible, Time-Saving, and Efficient Method for In Vitro Plant Regeneration from Potato Protoplasts. Plants 2021, 10, 781. [Google Scholar] [CrossRef] [PubMed]
- Sun, Y.; Zhang, X.; Huang, C.; Nie, Y.; Guo, X. Factors Influencing in vitro Regeneration from Protoplasts of Wild Cotton (G. Klotzschianum A) and RAPD Analysis of Regenerated Plantlets. Plant Growth Regul. 2005, 46, 79–86. [Google Scholar] [CrossRef]
- Khentry, Y.; Paradornuvat, A.; Tantiwiwat, S.; Phansiri, S.; Thaveechai, N. Protoplast Isolation and Culture of Dendrobium Sonia “Bom 17”. Agric. Nat. Resour. 2006, 40, 361–369. [Google Scholar]
- Tao, R.; Tamura, M.; Yonemori, K.; Sugiura, A. Plant Regeneration from Callus Protoplasts of Adult Japanese Persimmon (Diospyros kaki L.). Plant Sci. 1991, 79, 119–125. [Google Scholar] [CrossRef]
- Hu, X.; Yin, Y.; He, T. Plant Regeneration from Protoplasts of Gentiana Macrophylla Pall. Using Agar-Pool Culture. Plant Cell Tiss Organ Cult. 2015, 121, 345–351. [Google Scholar] [CrossRef]
- Masani, M.Y.A.; Noll, G.; Parveez, G.K.A.; Sambanthamurthi, R.; Prüfer, D. Regeneration of Viable Oil Palm Plants from Protoplasts by Optimizing Media Components, Growth Regulators and Cultivation Procedures. Plant Sci. 2013, 210, 118–127. [Google Scholar] [CrossRef]
- Borgato, L.; Pisani, F.; Furini, A. Plant Regeneration from Leaf Protoplasts of Solanum virginianum L. (Solanaceae). Plant Cell Tiss Organ Cult. 2007, 88, 247–252. [Google Scholar] [CrossRef]
- Kiełkowska, A.; Adamus, A. An Alginate-Layer Technique for Culture of Brassica oleracea L. Protoplasts. Vitr. Cell. Dev. Biol. Plant 2012, 48, 265–273. [Google Scholar] [CrossRef]
- Kang, H.H.; Naing, A.H.; Kim, C.K. Protoplast Isolation and Shoot Regeneration from Protoplast-Derived Callus of Petunia hybrida Cv. Mirage Rose. Biology 2020, 9, 228. [Google Scholar] [CrossRef] [PubMed]
- Avila-Peltroche, J.; Won, B.Y.; Cho, T.O. Protoplast Isolation and Regeneration from Hecatonema terminale (Ectocarpales, Phaeophyceae) Using a Simple Mixture of Commercial Enzymes. J. Appl. Phycol. 2019, 31, 1873–1881. [Google Scholar] [CrossRef]
- Fransz, P.F.; Leunissen, E.H.M.; Colijn-Hooymans, C.M. 2,4-Dichlorophenoxyacetic Acid Affects Mode and Frequency of Regeneration from Hypocotyl Protoplasts of Brassica oleracea. Protoplasma 1993, 176, 125–132. [Google Scholar] [CrossRef]
- Hussain, M.; Li, H.; Badri Anarjan, M.; Lee, S. Development of a General Protoplast-Mediated Regeneration Protocol for Brassica: Cabbage and Cauliflower as Examples. Hortic. Environ. Biotechnol. 2023. [Google Scholar] [CrossRef]
- Li, S.-F.; Ye, T.-W.; Xu, X.; Yuan, D.-Y.; Xiao, S.-X. Callus Induction, Suspension Culture and Protoplast Isolation in Camellia oleifera. Sci. Hortic. 2021, 286, 110193. [Google Scholar] [CrossRef]
- Inokuma, C.; Sugiura, K.; Cho, C.; Okawara, R.; Kaneko, S. Plant Regeneration from Protoplasts of Japanese Lawngrass. Plant Cell Rep. 1996, 15, 737–741. [Google Scholar] [CrossRef] [PubMed]
- Grzebelus, E.; Szklarczyk, M.; Baranski, R. An Improved Protocol for Plant Regeneration from Leaf- and Hypocotyl-Derived Protoplasts of Carrot. Plant Cell Tiss Organ Cult. 2012, 109, 101–109. [Google Scholar] [CrossRef]
- Zhang, C.-J.; Wang, H.-L.; Ma, Y.; Kang, Y.-Q. Regeneration of Haploid Plants from Isolated Microspores of Asparagus (Asparagus officinalis L.). Plant Cell Rep. 1994, 13, 637–640. [Google Scholar] [CrossRef]
- Assani, A.; Chabane, D.; Foroughi-Wehr, B.; Wenzel, G. An Improved Protocol for Microcallus Production and Whole Plant Regeneration from Recalcitrant Banana Protoplasts (Musa Spp.). Plant Cell Tiss Organ Cult. 2006, 85, 257–264. [Google Scholar] [CrossRef]
- Thomas, T.D. Isolation, Callus Formation and Plantlet Regeneration from Mesophyll Protoplasts of Tylophora indica (Burm. f.) Merrill: An Important Medicinal Plant. Vitr. Cell. Dev. Biol. Plant 2009, 45, 591. [Google Scholar] [CrossRef]
- Sandgrind, S.; Li, X.; Ivarson, E.; Ahlman, A.; Zhu, L.-H. Establishment of an Efficient Protoplast Regeneration and Transfection Protocol for Field Cress (Lepidium campestre). Front. Genome Ed. 2021, 3, 757540. [Google Scholar] [CrossRef] [PubMed]
- Deepa, A.V.; Anju, M.; Dennis Thomas, T. The Applications of TDZ in Medicinal Plant Tissue Culture. In Thidiazuron: From Urea Derivative to Plant Growth Regulator; Ahmad, N., Faisal, M., Eds.; Springer: Singapore, 2018; pp. 297–316. [Google Scholar] [CrossRef]
- Novikova, T.I.; Zaytseva, Y.G. TDZ-Induced Morphogenesis Pathways in Woody Plant Culture. In Thidiazuron: From Urea Derivative to Plant Growth Regulator; Ahmad, N., Faisal, M., Eds.; Springer: Singapore, 2018; pp. 61–94. ISBN 978-981-10-8004-3. [Google Scholar] [CrossRef]
- Skoog, F.; Miller, C.O. Chemical Regulation of Growth and Organ Formation in Plant Tissues Cultured in vitro. Symp. Soc. Exp. Biol. 1957, 11, 118–130. [Google Scholar] [PubMed]
- Mok, M.C.; Mok, D.W.S.; Turner, J.E.; Mujer, C.V. Biological and Biochemical Effects of Cytokinin-Active Phenylurea Derivatives in Tissue Culture Systems. HortScience 1987, 22, 1194–1197. [Google Scholar] [CrossRef]
- Thomas, J.C.; Katterman, F.R. Cytokinin Activity Induced by Thidiazuron. Plant Physiol. 1986, 81, 681–683. [Google Scholar] [CrossRef] [PubMed]
- Nisler, J. TDZ: Mode of Action, Use and Potential in Agriculture. In Thidiazuron: From Urea Derivative to Plant Growth Regulator; Ahmad, N., Faisal, M., Eds.; Springer: Singapore, 2018; pp. 37–59. ISBN 978-981-10-8004-3. [Google Scholar] [CrossRef]
- Larkin, P.J.; Brettell, R.; Ryan, S.; Scowcroft, W. Protoplasts and Variation from Culture. In Protoplasts 1983: Lecture Proceedings; Potrykus, I., Harms, C.T., Hinnen, A., Hütter, R., King, P.J., Shillito, R.D., Eds.; EXS 46: Experientia Supplementum; Birkhäuser: Basel, Switzerland, 1983; pp. 51–56. ISBN 978-3-0348-6776-4. [Google Scholar] [CrossRef]
- Dewir, Y.H.; Nurmansyah; Naidoo, Y.; Teixeira da Silva, J.A. Thidiazuron-Induced Abnormalities in Plant Tissue Cultures. Plant Cell Rep. 2018, 37, 1451–1470. [Google Scholar] [CrossRef] [PubMed]
- Roy, A.R.; Sajeev, S.; Pattanayak, A.; Deka, B.C. TDZ Induced Micropropagation in Cymbidium giganteum Wall. Ex Lindl. and Assessment of Genetic Variation in the Regenerated Plants. Plant Growth Regul. 2012, 68, 435–445. [Google Scholar] [CrossRef]
- Zhou, Y.; Deng, R.; Xu, X.; Yang, Z.; Zhou, Y.; Deng, R.; Xu, X.; Yang, Z. Isolation of Mesophyll Protoplasts from Tea (Camellia sinensis) and Localization Analysis of Enzymes Involved in the Biosynthesis of Specialized Metabolites. Beverage Plant Res. 2021, 1, 2. [Google Scholar] [CrossRef]
- Svozil, J.; Gruissem, W.; Baerenfaller, K. Meselect—A Rapid and Effective Method for the Separation of the Main Leaf Tissue Types. Front. Plant Sci. 2016, 7, 1701. [Google Scholar] [CrossRef]
- Xue, Y.; Hiti-Bandaralage, J.C.A.; Jambuthenne, D.T.; Zhao, Z.; Mitter, N. Micropropagation of Duboisia Species via Shoot Tip Meristem. Horticulturae 2023, 9, 1313. [Google Scholar] [CrossRef]
- Xue, Y.; Hiti-Bandaralage, J.C.A.; Mitter, N. Micropropagation of Duboisia Species: A Review on Current Status. Agronomy 2023, 13, 797. [Google Scholar] [CrossRef]
- Mason, P.; Hiti-Bandaralage, J.; Xue, Y.; Mitter, N.; Henry, R. Advancing the Duboisia Industry for Sustainable Alkaloids. In Proceedings of the TropAg 2022, Brisbane, Australia, 31 October–2 November 2022. [Google Scholar] [CrossRef]
- Zhang, Y.; Su, J.; Duan, S.; Ao, Y.; Dai, J.; Liu, J.; Wang, P.; Li, Y.; Liu, B.; Feng, D.; et al. A Highly Efficient Rice Green Tissue Protoplast System for Transient Gene Expression and Studying Light/Chloroplast-Related Processes. Plant Methods 2011, 7, 30. [Google Scholar] [CrossRef] [PubMed]
- Gamborg, O.L.; Miller, R.A.; Ojima, K. Nutrient Requirements of Suspension Cultures of Soybean Root Cells. Exp. Cell Res. 1968, 50, 151–158. [Google Scholar] [CrossRef] [PubMed]
- Kaur, N.D.; Vyvadilová, M.; Klíma, M.; Bechyně, M. A Simple Procedure for Mesophyll Protoplast Culture and Plant Regeneration in Brassica oleracea L. and Brassica napus L. Czech J. Genet. Plant Breed. 2006, 42, 103–110. [Google Scholar] [CrossRef]
- Tricoli, D.M.; Hein, M.B.; Carnes, M.G. Culture of Soybean Mesophyll Protoplasts in Alginate Beads. Plant Cell Rep. 1986, 5, 334–337. [Google Scholar] [CrossRef]
- McCown, B.H. Woody Plant Medium (WPM)—A Mineral Nutrient Formulation for Microculture for Woody Plant Species. Hort. Sci. 1981, 16, 453. [Google Scholar]
- Kao, K.N.; Michayluk, M.R. Nutritional Requirements for Growth of Vicia hajastana Cells and Protoplasts at a Very Low Population Density in Liquid Media. Planta 1975, 126, 105–110. [Google Scholar] [CrossRef]
- Murashige, T.; Skoog, F. A Revised Medium for Rapid Growth and Bio Assays with Tobacco Tissue Cultures. Physiol. Plant. 1962, 15, 473–497. [Google Scholar] [CrossRef]

| Cellulysin/Macerozyme Concentration (%, w/v) | Yield (×105 Cells g−1 FW) | Viability (%) |
|---|---|---|
| 1/0.25 | 1.5 ± 0.4 a | 74.1 ± 6.5 a |
| 2/0.5 | 8.9 ± 1.9 b | 80.9 ± 8.9 a |
| Protoplast Density (×105 Cells g−1 FW) | Cell Division Frequency | Microcalli Induction Frequency |
|---|---|---|
| 0.5 | 33.2 ± 6.3 a | 17.9 ± 7.8 a |
| 1 | 31.7 ± 5.9 a | 14.8 ± 4.1 a |
| 5 | 21.9 ± 2.8 b | 5.9 ± 3.4 b |
| Hormone Concentration (mg L−1) | Shoot Regeneration (%) | ||
|---|---|---|---|
| TDZ | BA | NAA | |
| 0 | 0 | 0 | 0 |
| 0 | 2 | 0 | 0 |
| 0 | 5 | 0 | 0 |
| 1.5 | 0 | 0 | 63.3 ± 12.2 a |
| 1.5 | 1.5 | 0 | 34.2 ± 8.0 b |
| 1.5 | 0 | 0.1 | 27.9 ± 23.0 b |
| 1.5 | 0 | 0.5 | 0 |
Disclaimer/Publisher’s Note: The statements, opinions and data contained in all publications are solely those of the individual author(s) and contributor(s) and not of MDPI and/or the editor(s). MDPI and/or the editor(s) disclaim responsibility for any injury to people or property resulting from any ideas, methods, instructions or products referred to in the content. |
© 2023 by the authors. Licensee MDPI, Basel, Switzerland. This article is an open access article distributed under the terms and conditions of the Creative Commons Attribution (CC BY) license (https://creativecommons.org/licenses/by/4.0/).
Share and Cite
Xue, Y.; Hiti-Bandaralage, J.C.A.; Hu, Z.; Zhao, Z.; Mitter, N. First Report on Mesophyll Protoplast Isolation and Regeneration System for the Duboisia Species. Plants 2024, 13, 40. https://doi.org/10.3390/plants13010040
Xue Y, Hiti-Bandaralage JCA, Hu Z, Zhao Z, Mitter N. First Report on Mesophyll Protoplast Isolation and Regeneration System for the Duboisia Species. Plants. 2024; 13(1):40. https://doi.org/10.3390/plants13010040
Chicago/Turabian StyleXue, Yuxin, Jayeni Chathurika Amarathunga Hiti-Bandaralage, Zhangpan Hu, Zizhu Zhao, and Neena Mitter. 2024. "First Report on Mesophyll Protoplast Isolation and Regeneration System for the Duboisia Species" Plants 13, no. 1: 40. https://doi.org/10.3390/plants13010040
APA StyleXue, Y., Hiti-Bandaralage, J. C. A., Hu, Z., Zhao, Z., & Mitter, N. (2024). First Report on Mesophyll Protoplast Isolation and Regeneration System for the Duboisia Species. Plants, 13(1), 40. https://doi.org/10.3390/plants13010040

